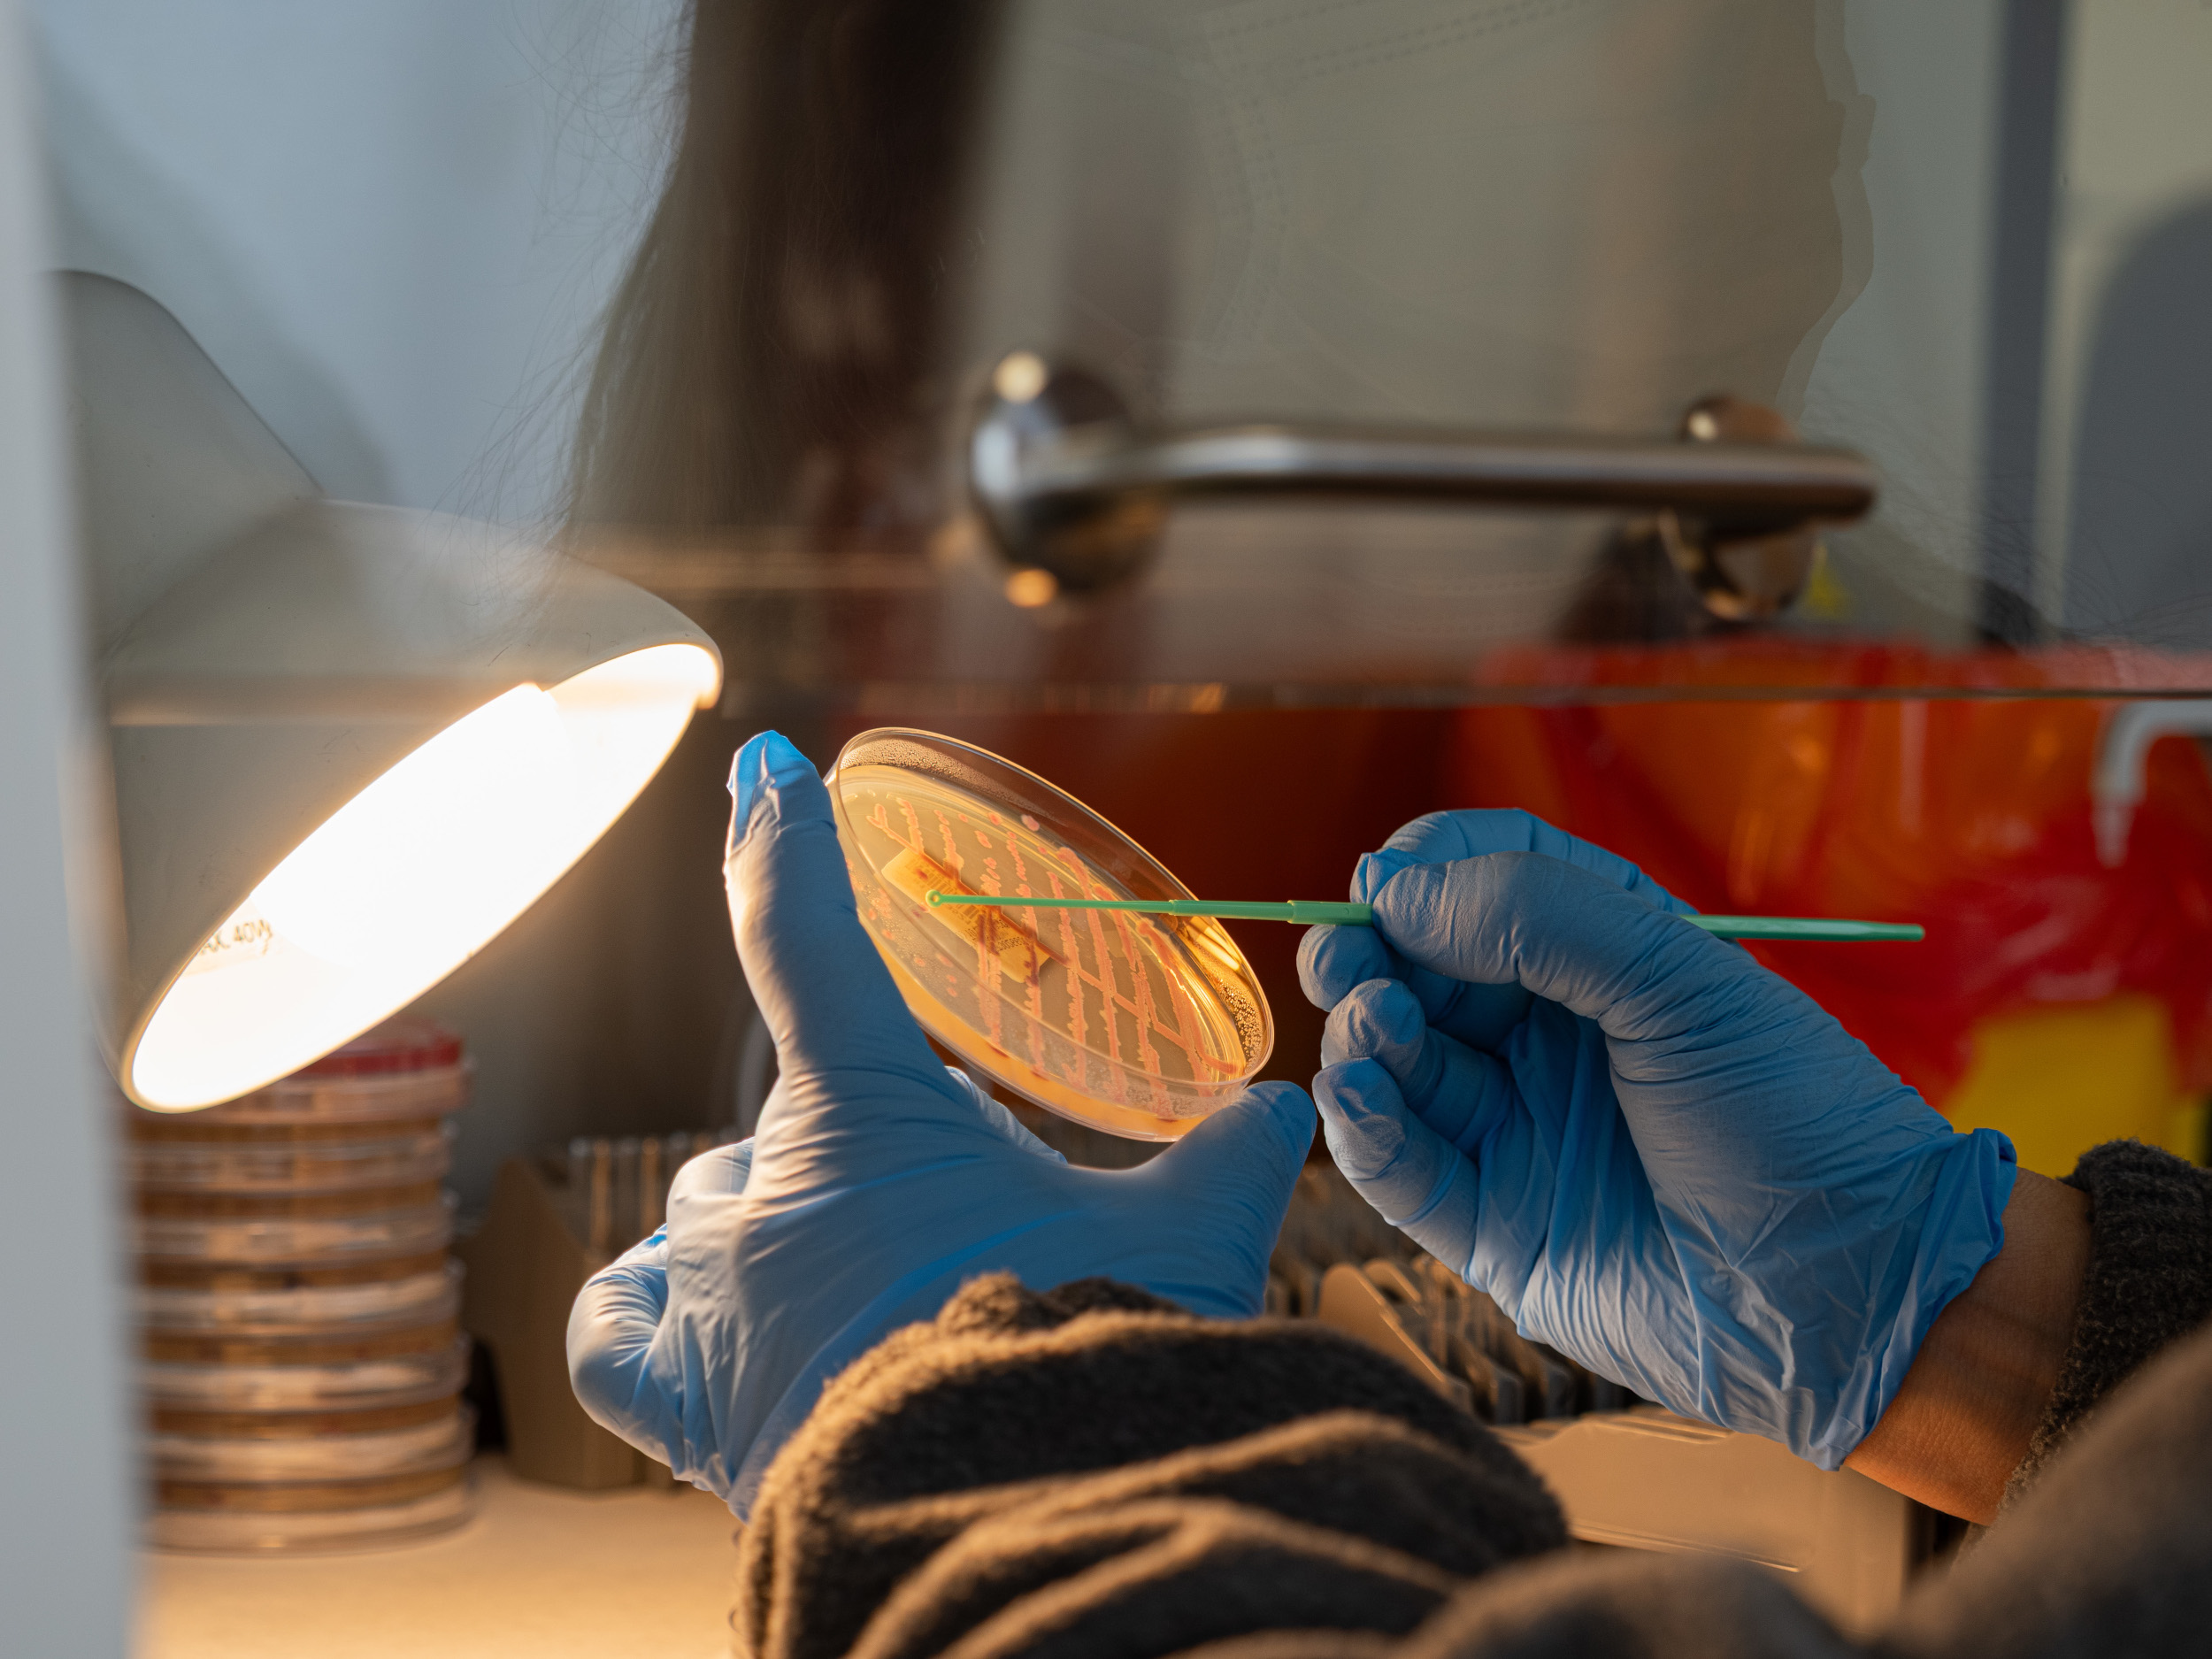
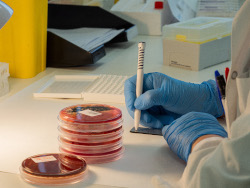

Epidemiologia clínica
Convertim les dades en coneixement per impulsar la recerca i la salut del territori
Què ens fa diferents?
Oferim assessorament complet, des de la formulació de la pregunta fins a la publicació del projecte

Facilitadors en la interlocució amb l’IRIS-CC i el CEIM IRIS-CC: garantim la coordinació i el rigor ètic i científic.

Gestió integrada de la vigilància epidemiològica: coordinem totes les activitats de notificació i seguiment dins del Cercle SiS.
Sobre el servei
El Servei d’Epidemiologia Clínica del Cercle SiS desenvolupa quatre funcions principals:
- Suport i impuls a la recerca dels professionals del Cercle SiS, des de l’elaboració de la pregunta de recerca fins a la publicació dels resultats.
- Gestió de l’oficina de cribratge de càncer del Consorci Hospitalari de Vic.
- Vigilància epidemiològica
- Suport a les decisions clíniques
La unitat està formada per dos metges epidemiòlegs especialistes en salut pública, una estadística, un infermer de recerca i una administrativa de suport tècnic.
El Servei d’Epidemiologia Clínica també participa en el desenvolupament i revisió de protocols institucionals (com els d’immunosupressió o prevenció d’infeccions) i en projectes d’adequació de la pràctica clínica. L’objectiu és promoure una assistència basada en l’evidència i contribuir a la millora contínua de la qualitat assistencial.

L’àrea de recerca ofereix suport metodològic als professionals del Cercle Sis, tant en investigació clínica com qualitativa i quantitativa.
Oferim:
- Acompanyament en el disseny i desenvolupament de projectes.
- Suport en l’anàlisi estadística, la presentació de resultats i les publicacions.
- Identificació de necessitats formatives en recerca i metodologies científiques.
També s’actua com a punt d’enllaç amb l’Institut de Recerca de la Catalunya Central (IRIS-CC) i amb el Comitè d’Ètica d’Investigació (CEIM IRIS-CC).
A finals de 2024, el servei comptava amb 102 projectes actius, amb 9 projectes de recerca amb finançament competitiu, 42 articles publicats i 10 doctorats industrials en curs subvencionats per l'AGAUR.

La unitat gestiona el cribratge de càncer de la població d’Osona, adreçats a persones d'entre 50 a 69 anys, en coordinació amb el Departament de Salut.
Això suposa:
- 10.000 dones incorporades anualment al programa de cribratge de càncer de mama.
- 20.000 homes i dones incorporats anualment al programa de cribratge de càncer de còlon i recte.
- 10.000 mamografies anuals i 500-600 colonoscòpies derivades (3% de positivitat a la prova de sang oculta en femta).
La unitat manté actualitzat el registre poblacional, gestiona les citacions i acompanya el pacient durant tot el procés diagnòstic i terapèutic.
El servei coordina la vigilància epidemiològica dins del Cercle SiS, amb una visió de salut pública i territorial.
Entre les seves funcions:
- Notificació a la Direcció General de Salut Pública de totes les Malalties de Declaració Obligatòria (MDO).
- Estudi de tots els brots infecciosos detectats als centres del CHV i la FHSC.
- Participació a la Comissió de Malalties Infeccioses del CHV-FHSC.

El servei ofereix suport a les decisions clíniques i a l’adequació de la pràctica clínica: participació activa en protocols institucionals (immunosupressió), així com co-lideratge de la comissió d’adequació de la pràctica clínica.

El Servei d’Epidemiologia Clínica del Cercle SiS desenvolupa quatre funcions principals:
- Suport i impuls a la recerca dels professionals del Cercle SiS, des de l’elaboració de la pregunta de recerca fins a la publicació dels resultats.
- Gestió de l’oficina de cribratge de càncer del Consorci Hospitalari de Vic.
- Vigilància epidemiològica
- Suport a les decisions clíniques
La unitat està formada per dos metges epidemiòlegs especialistes en salut pública, una estadística, un infermer de recerca i una administrativa de suport tècnic.
El Servei d’Epidemiologia Clínica també participa en el desenvolupament i revisió de protocols institucionals (com els d’immunosupressió o prevenció d’infeccions) i en projectes d’adequació de la pràctica clínica. L’objectiu és promoure una assistència basada en l’evidència i contribuir a la millora contínua de la qualitat assistencial.

L’àrea de recerca ofereix suport metodològic als professionals del Cercle Sis, tant en investigació clínica com qualitativa i quantitativa.
Oferim:
- Acompanyament en el disseny i desenvolupament de projectes.
- Suport en l’anàlisi estadística, la presentació de resultats i les publicacions.
- Identificació de necessitats formatives en recerca i metodologies científiques.
També s’actua com a punt d’enllaç amb l’Institut de Recerca de la Catalunya Central (IRIS-CC) i amb el Comitè d’Ètica d’Investigació (CEIM IRIS-CC).
A finals de 2024, el servei comptava amb 102 projectes actius, amb 9 projectes de recerca amb finançament competitiu, 42 articles publicats i 10 doctorats industrials en curs subvencionats per l'AGAUR.

La unitat gestiona el cribratge de càncer de la població d’Osona, adreçats a persones d'entre 50 a 69 anys, en coordinació amb el Departament de Salut.
Això suposa:
- 10.000 dones incorporades anualment al programa de cribratge de càncer de mama.
- 20.000 homes i dones incorporats anualment al programa de cribratge de càncer de còlon i recte.
- 10.000 mamografies anuals i 500-600 colonoscòpies derivades (3% de positivitat a la prova de sang oculta en femta).
La unitat manté actualitzat el registre poblacional, gestiona les citacions i acompanya el pacient durant tot el procés diagnòstic i terapèutic.
El servei coordina la vigilància epidemiològica dins del Cercle SiS, amb una visió de salut pública i territorial.
Entre les seves funcions:
- Notificació a la Direcció General de Salut Pública de totes les Malalties de Declaració Obligatòria (MDO).
- Estudi de tots els brots infecciosos detectats als centres del CHV i la FHSC.
- Participació a la Comissió de Malalties Infeccioses del CHV-FHSC.

El servei ofereix suport a les decisions clíniques i a l’adequació de la pràctica clínica: participació activa en protocols institucionals (immunosupressió), així com co-lideratge de la comissió d’adequació de la pràctica clínica.



